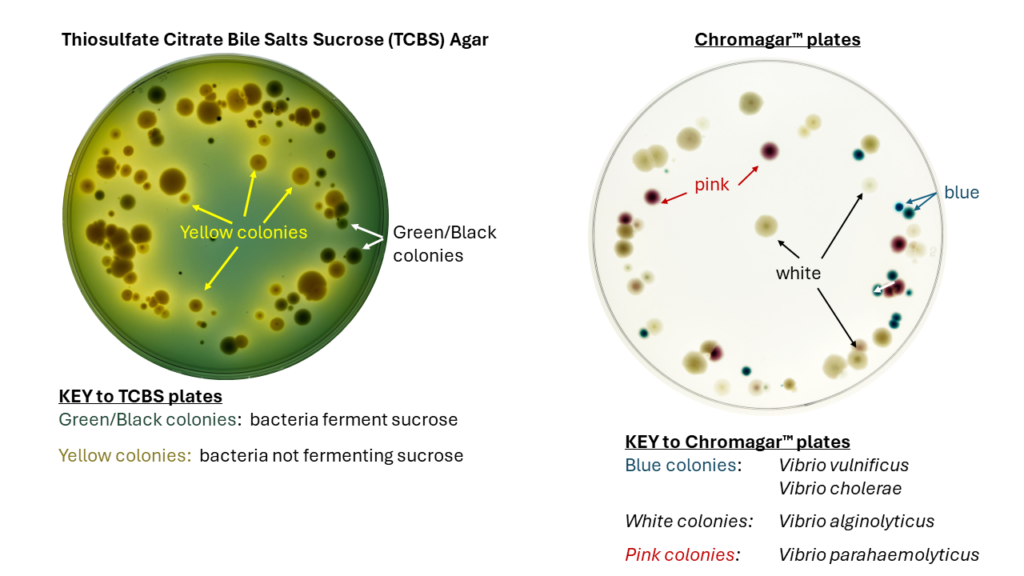

About Grice Marine Lab Vibrio Sampling Data
What is the Grice Marine Lab Vibrio Sampling Data?
Simply put, it is hopefully the beginning of a long-term, single site survey of Vibrio bacteria in the water collected behind Grice Marine Lab which is located next to Charleston Harbor on James Island, South Carolina, USA. You gotta start somewhere and sometime.
Why did we start this project?
Firstly, we were inspired by work done by Charleston Waterkeeper. This outstanding citizen science organization tracks bacterial coliforms and advocates for clean water.
Secondly, we couldn’t find any long-term data for Vibrio in Charleston Harbor. Climate change and associated sea-level rise will push sea water into places that don’t have sea water. As a result, the seawater-associated bacteria that cause disease will follow. We wanted to create a simple record that could be accessed by anyone so that anyone could gain a little insight into:
•When are Vibrio levels highest in Charleston Harbor?
•When are Vibrio species associated with disease abundant?
•Is water temperature a good yardstick from which to predict Vibrio levels?
Thirdly, we keep hearing about Vibrios from our friends R. Sean Norman, Ph.D. a professor at University of South Carolina and Heather Fullerton, Ph.D. an associate professor at the College of Charleston. These are the experts who do great science to understand antibiotic resistance and external factors (temperature, rainfall, salinity etc…) that influence Vibrio growth and pathogenicity. We look to them for answers.
Lastly, we are just curious people who want to observe the natural world.
What are Vibrio bacteria?
The name ‘Vibrio” describes a genus within the family Vibrionaceae. According to the database “The List of Prokaryotic names with Standing Nomenclature” the etymology of the name Vibrio is latin in origin and literally stands for “that which vibrates, the vibrating, darting organism”. Who knew?
Bacteria that are grouped into the “Vibrio” genus primarily thrive in warm sea water (>30 ppt) and/or brackish water (0.5-30 ppt), but not so much in fresh water (<0.5 ppt). However, the Vibrio species that cause cholera have been found in fresh water (Daboul et al. 2017) and just because it is fresh water doesn’t mean Vibrio aren’t present.
How many Vibrio species are there?
Honestly nobody knows because new species are constantly being discovered, genomes sequenced, and scientists debating; however, according to Vibrio Clade 3.0 (Jiang C. et al. 2021) there are at least 128 species that have been described for the genus Vibrio. The List of Prokaryotic names with Standing Nomenclature (https://lpsn.dsmz.de/) list 178 species for the genus Vibrio. It’s safe to say there are more than 100.
Are Vibrio abundant in the Ocean?
Yes, but not super abundant compared to all the other bacteria. For example, In Dongshan Bay, China, Vibrio sp. only represented 0.56% – 0.79% of the bacterial community (Xu et al., 2021). Along the coast of Eastern Australia, Vibrio sp. represented only about 0.01% of the total bacterial community (Williams et al., 2022). There are reports where Vibrio sp. comprise greater than 10% the natural bacterial community, but these are usually due to pollution or some natural disaster.
What is the role of Vibrio in the environment?
That’s a pretty big question and best summarized in Jay Grimes’s mini-review published in Microbial Ecology (2020). Some Vibrio species are symbionts and co-exist within host species (sharks, squid). Other Vibrio simply participate in carbon cycling in the ocean (they eat and excrete carbon containing molecules). And then there are some Vibrios that cause disease in animals (oysters, fish), including humans.
Which Vibrio cause disease in humans?
A few of them are the main culprits that cause “Vibriosis”:
Vibrio vulnificus, Vibrio cholerae, Vibrio parahaemolyticus, Vibrio alginolyticus
But just because a Vibrio species is found in water doesn’t mean it’s a pathogen. In order for Vibrio species to hurt humans they have to be consumed or gain entry through a wound. And even then the Vibrio species have to turn-on all the necessary genes to be pathogenic. The CDC does a good job of educating on Vibrio infections and listing disease causing Vibrios.
Why Chromagar™ and TCBS agar?
We started plating water behind the Grice Marine Laboratory, James Island, SC in March of 2023. We started with TCBS plates because they are selective for Vibrio, but not completely selective. That means, some bacteria like Aeromonas, Shewenella, and Photobacterium will grow on TCBS.
About a month after we started plating water behind Grice Marine Lab, Dr. Norman (Univ. South Carolina Prof mentioned above) told us about ChromAgar™ plates to discern the Vibrio species that are most likely to cause Vibriosis in humans (Thanks Dr. Norman!). We thought this was a great idea and started plating both plates starting the end of March 2023. This is the reason for the difference in sampling start date between TCBS and Chromagar™ plates.
The agars we use are linked below (not an endorsement because they don’t pay us):
TCBS agar: https://www.sigmaaldrich.com/US/en/product/sial/86348
CHROMagar™ Vibrio agar : https://www.chromagar.com/en/product/chromagar-vibrio/
Check out the picture below
TCBS AGAR PLATES (Left) and CHROMAGAR PLATES (Right)
Plating
When we started this project there was one word that came to mind….SIMPLE. We started by plating 100µL (0.1mL) of water and using a glass pipet shaped by flame to spread the water across the plate for about 1 minute. Once we started seeing way too many colonies to count by eye, we decided to use 50µL (0.05mL) water. Plates are incubated upside down at 37ºC overnight (usually 18 hours).
Counting
We use a cheap light pad purchased from Amazon to count colonies. Everything is done manually and colonies are identified by eye. We also take photos of each plate and toss it into our google drive for reference. The google drive folder is really large so we don’t post all images due to storage space. Colony numbers are entered into the spreadsheet along with water temperature and observations about the tide and rainfall. We try to keep updated images from the latest sampling period in a slide show posted here.
Sampling time
Because this is a volunteer project, we decided to sample once a week to start. We chose to sample mid-tide instead of low or high because we wanted to get an average picture of Vibrio in the harbor. Plus it would take an enormous amount of resources and effort to sample at multiple points across the tidal cycle even once a week.
Where are the replicates?
See above. One day we hope to be able to do replicates and multiple sites at multiple times. At this point it’s two people driving this bus. College of Charleston, Department of Biology has supplied space and enough funds to purchase reagents.
Who can use the data?
Any curious person can copy and paste the data and use it. Seriously, I don’t care. That’s why I made this site. Make observations!!!! Look at the natural world and ask questions. If you have questions, I can be reached at janechmg@cofc.edu
Literature Cited
Daboul J, Weghorst L, DeAngelis C, Plecha SC, Saul-McBeth J, Matson JS. Characterization of Vibrio cholerae isolates from freshwater sources in northwest Ohio. PLoS One. 2020 Sep 3;15(9):e0238438. doi: 10.1371/journal.pone.0238438. PMID: 32881972; PMCID: PMC7470319.
Parte, A.C., Sardà Carbasse, J., Meier-Kolthoff, J.P., Reimer, L.C. and Göker, M. (2020). List of Prokaryotic names with Standing in Nomenclature (LPSN) moves to the DSMZ. International Journal of Systematic and Evolutionary Microbiology, 70, 5607-5612; DOI: 10.1099/ijsem.0.004332
Jiang, C., Tanaka, M., Nishikawa, S. et al. Vibrio Clade 3.0: New Vibrionaceae Evolutionary Units Using Genome-Based Approach. Curr Microbiol 79, 10 (2022). https://doi.org/10.1007/s00284-021-02725-0
Grimes, D.J. The Vibrios: Scavengers, Symbionts, and Pathogens from the Sea. Microb Ecol 80, 501–506 (2020). https://doi.org/10.1007/s00248-020-01524-7
Xu W, Lin W, Wang Z, Gao Y, Luo Y, Grossart HP, Guo Y, Gao Q, Huang L, Luo Z. Disentangling the abundance and structure of Vibrio communities in a semi-enclosed Bay with mariculture (Dongshan Bay, Southern China). Comput Struct Biotechnol J. 2021 Aug 5;19:4381-4393. doi: 10.1016/j.csbj.2021.07.040. PMID: 34429854; PMCID: PMC8365367.
Williams, N.L.R.; Siboni, N.; King, W.L.; Balaraju, V.; Bramucci, A.; Seymour, J.R. Latitudinal Dynamics of Vibrio along the Eastern Coastline of Australia. Water 2022, 14, 2510. https://doi.org/10.3390/w14162510
